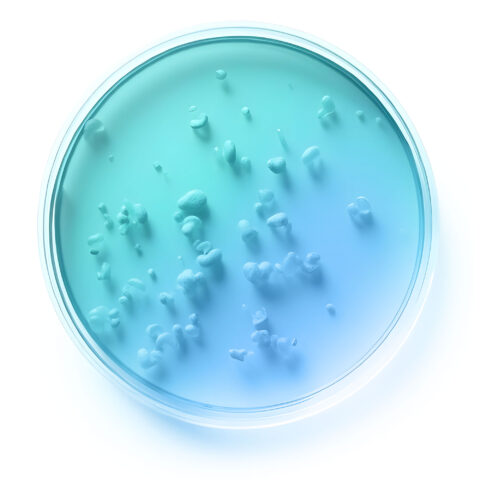
Probiotic cell

We’ve published more than 50 clinical trials showing our strains’ potential in 9 Wellness Areas
Precision probiotics for leading-edge developments powered by science
As probiotic leaders, we support our partners throughout product lifespan with research & development, market access, and marketing specialists. We adapt to our partners’ aspirations and needs through co-development of probiotic solutions following market trends.
Our unique approach to innovation is helping us – and our partners – break down boundaries, illuminate new opportunities in the promising biotic category.
Our Proven Precision Probiotic Solutions: From Strains to Market Ready Products

Probiotic strains
Unique strains with characterized mechanisms of action

Probiotic formulas
Scientifically- documented, forward-looking probiotic solutions

Ready-to-market probiotic products
Premium probiotic products and formulations adapted to your market
New

Discover a new era in probiotic innovation
Get access to our latest Whitepaper
Our identity
Pioneering precision probiotic solutions
We leverage distinctive probiotic strains with exceptional genetic traits to explore their mechanisms of action, providing innovative and targeted solutions for health benefits in the functional food and dietary supplement industries.

50+ published clinical trials

500+ unique strains

200+ patents

80+ markets

20+ years
Let's connect
Ready to succeed in the growing probiotic space with cutting-edge, science-powered solutions?
Connect with one of our experts to start your journey
Get in touchLatest news
March 17, 2026
New Clinical Study Highlights Postbiotic Support for Skin Elasticity with L. sakei proBio65®
In December 2025, a randomized, double-blind, placebo-controlled clinical study was published in the Journal of Cosmetic Dermatology, evaluating orally administered heat-treated L. sakei proBio65® in healthy women aged 30 to...